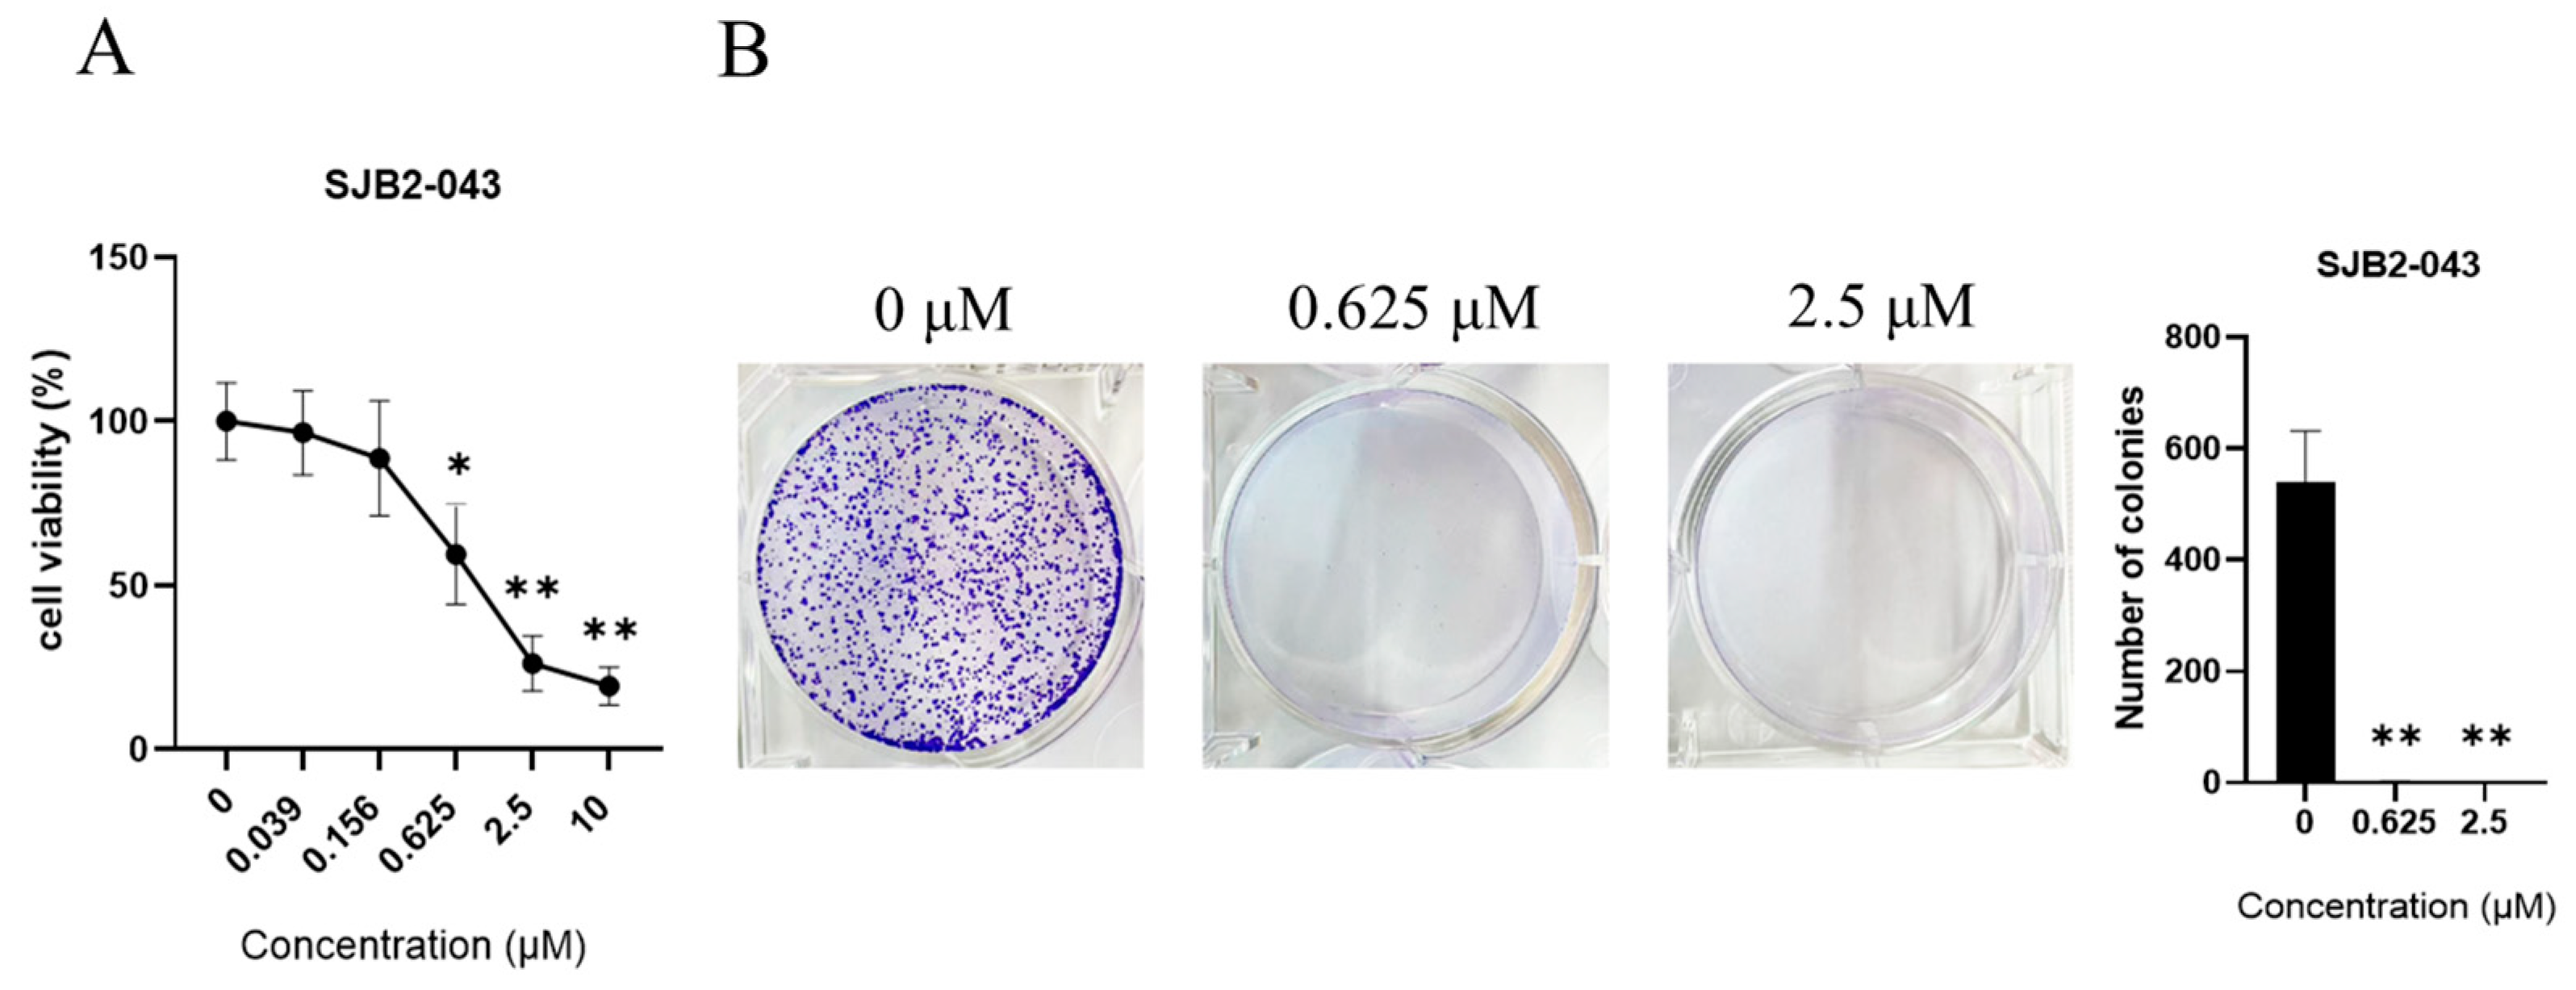
Cimb 47 00155 g003

SJB2-043, a USP1 Inhibitor, Suppresses A549 Cell Proliferation, Migration, and EMT via Modulation of PI3K/AKT/mTOR, MAPK, and Wnt Signaling Pathways
Abstract
1. Introduction
2. Materials and Methods
2.1. Drug
2.2. Cell Culture
2.3. Correlation Analysis Between USP1 and NSCLC Prognosis
2.4. RNA Sequencing, Differential Expression Analysis, and Kyoto Encyclopedia of Genes and Genomes (KEGG)
2.5. CCK-8 Assay for Cell Viability
2.6. Colony Formation (CF) Assay
2.7. Flow Cytometry (FCM) Analysis of Cell Cycle with Propidium Iodide (PI) Staining
2.8. Detection of Cell Apoptosis Utilizing Annexin V-FITC Apoptosis Kit
2.9. Wound-Healing Assay
2.10. WB Analysis
2.11. Statistical Analysis
3. Results
3.1. Identification of USP1 as an Oncogene in NSCLC
3.2. RNA-Seq and Bioinformatics Analysis of SJB2-043
3.3. SJB2-043 Inhibits A549 Cell Proliferation and Inhibits the Clonogenic Ability of A549 Cells
3.4. SJB2-043 Promotes Apoptosis in A549 Cells
3.5. SJB2-043 Arrests A549 Cells in the G2 Phase
3.6. SJB2-043 Inhibits the Migration Capability of A549 Cells
3.7. SJB2-043 Downregulates N-Cadherin, but Upregulates the Epithelial Marker E-Cadherin, ZO-1, and Occludin in A549 Cells
3.8. SJB2-043 Downregulates the MAPK Pathway in A549 Cells
3.9. SJB2-043 Suppresses the Wnt/β-Catenin Pathway in A549 Cells
3.10. SJB2-043 Inhibits the PI3K/AKT/mTOR Pathway in A549 Cells
4. Discussion
5. Conclusions
Supplementary Materials
Author Contributions
Funding
Institutional Review Board Statement
Informed Consent Statement
Data Availability Statement
Conflicts of Interest
Abbreviations
| EMT | epithelial–mesenchymal transition |
| NSCLC | non-small cell lung cancer |
| DUBs | Deubiquitinating enzymes |
| USP1 | ubiquitin-specific peptidase 1 |
| KEGG | Kyoto Encyclopedia of Genes and Genomes |
| RNA-seq | RNA-sequencing |
| FCM | Flow cytometry |
| PI | propidium iodide |
| PBS | phosphate buffered saline |
| CF | Colony formation |
| WB | Western blot |
| DEGs | differentially expressed genes |
References
- Bray, F.; Laversanne, M.; Sung, H.; Ferlay, J.; Siegel, R.L.; Soerjomataram, I.; Jemal, A. Global cancer statistics 2022: GLOBOCAN estimates of incidence and mortality worldwide for 36 cancers in 185 countries. CA A Cancer J. Clin. 2024, 74, 229–263. [Google Scholar] [CrossRef] [PubMed]
- Shokoohi, A.; Al Hashami, Z.; Moore, S.; Pender, A.; Wong, S.K.; Wang, Y.; Leung, B.; Wu, J.; Ho, C. Effect of targeted therapy and immunotherapy on advanced nonsmall-cell lung cancer outcomes in the real world. Cancer Med. 2022, 11, 86–93. [Google Scholar] [CrossRef] [PubMed]
- Harrison, P.T.; Vyse, S.; Huang, P.H. Rare epidermal growth factor receptor (EGFR) mutations in non-small cell lung cancer. Semin. Cancer Biol. 2020, 61, 167–179. [Google Scholar] [CrossRef] [PubMed]
- Bajbouj, K.; Al-Ali, A.; Ramakrishnan, R.K.; Saber-Ayad, M.; Hamid, Q. Histone Modification in NSCLC: Molecular Mechanisms and Therapeutic Targets. Int. J. Mol. Sci. 2021, 22, 11701. [Google Scholar] [CrossRef] [PubMed]
- Wu, L.; Lin, L.; Yu, M.; Li, H.; Dang, Y.; Liang, H.; Chen, G.; Muhetaer, H.; Zheng, G.; Li, J.; et al. Antitumor Activity of USP7 Inhibitor GNE-6776 in Non-Small Cell Lung Cancer Involves Regulation of Epithelial-Mesenchymal Transition, Cell Cycle, Wnt/β-Catenin, and PI3K/AKT/mTOR Pathways. Pharmaceuticals 2025, 18, 245. [Google Scholar] [CrossRef]
- Torres-Sanchez, A.; Torres, G.; Estrada, S.; Perez, D.; Garcia, C.; Milian, M.; Velazquez, E.; Molina, V.; Delgado, Y. Unraveling the Impact of Six Pentacyclic Triterpenes Regulating Metabolic Pathways on Lung Carcinoma Cells. Pharmaceuticals 2024, 17, 694. [Google Scholar] [CrossRef] [PubMed]
- To, K.; Chow, J.; Cheung, K.M.; Cho, W. Circumvention of Gefitinib Resistance by Repurposing Flunarizine via Histone Deacetylase Inhibition. ACS Pharmacol. Transl. Sci. 2023, 6, 1531–1543. [Google Scholar] [CrossRef]
- Zhang, N.; Wang, Q.; Lu, Y.; Wang, F.; He, Z. The deubiquitinating enzyme USP11 regulates breast cancer progression by stabilizing PGAM5. Breast Cancer Res. 2024, 26, 135. [Google Scholar] [CrossRef]
- Antao, A.M.; Tyagi, A.; Kim, K.; Ramakrishna, S. Advances in Deubiquitinating Enzyme Inhibition and Applications in Cancer Therapeutics. Cancers 2020, 12, 1579. [Google Scholar] [CrossRef] [PubMed]
- Song, B.; Jiang, Y.; Jiang, Y.; Lin, Y.; Liu, J. ML323 suppresses the progression of ovarian cancer via regulating USP1-mediated cell cycle. Front. Genet. 2022, 13, 917481. [Google Scholar] [CrossRef]
- Liu, P.; Chen, Z.; Guo, Y.; He, Q.; Pan, C. Recent advances in small molecule inhibitors of deubiquitinating enzymes. Eur. J. Med. Chem. 2025, 287, 117324. [Google Scholar] [CrossRef] [PubMed]
- Niu, Z.; Li, X.; Feng, S.; Huang, Q.; Zhuang, T.; Yan, C.; Qian, H.; Ding, Y.; Zhu, J.; Xu, W. The deubiquitinating enzyme USP1 modulates ERalpha and modulates breast cancer progression. J. Cancer 2020, 11, 6992–7000. [Google Scholar] [CrossRef] [PubMed]
- Kemp, M. Recent Advances in the Discovery of Deubiquitinating Enzyme Inhibitors. Prog. Med. Chem. 2016, 55, 149–192. [Google Scholar] [CrossRef] [PubMed]
- Yu, Z.; Tong, L.; Ma, C.; Song, H.; Wang, J.; Chai, L.; Wang, C.; Wang, M.; Wang, C.; Yan, R.; et al. The UAF1-USP1 Deubiquitinase Complex Stabilizes cGAS and Facilitates Antiviral Responses. J. Immunol. 2024, 212, 295–301. [Google Scholar] [CrossRef]
- Woo, S.M.; Kim, S.; Seo, S.U.; Kim, S.; Park, J.W.; Kim, G.; Choi, Y.R.; Hur, K.; Kwon, T.K. Inhibition of USP1 enhances anticancer drugs-induced cancer cell death through downregulation of survivin and miR-216a-5p-mediated upregulation of DR5. Cell Death Dis. 2022, 13, 821. [Google Scholar] [CrossRef] [PubMed]
- Wang, Z. Cell Cycle Progression and Synchronization: An Overview. Methods Mol. Biol. 2022, 2579, 3–23. [Google Scholar] [CrossRef]
- Liu, S.; Xiang, Y.; Wang, B.; Gao, C.; Chen, Z.; Xie, S.; Wu, J.; Liu, Y.; Zhao, X.; Yang, C.; et al. USP1 promotes the aerobic glycolysis and progression of T-cell acute lymphoblastic leukemia via PLK1/LDHA axis. Blood Adv. 2023, 7, 3099–3112. [Google Scholar] [CrossRef]
- Kim, Y.J.; Lee, Y.; Shin, H.; Hwang, S.; Park, J.; Song, E.J. Ubiquitin–proteasome system as a target for anticancer treatment—An update. Arch. Pharm. Res. 2023, 46, 573–597. [Google Scholar] [CrossRef] [PubMed]
- Guan, X.; Wang, Y.; Yu, W.; Wei, Y.; Lu, Y.; Dai, E.; Dong, X.; Zhao, B.; Hu, C.; Yuan, L.; et al. Blocking Ubiquitin-Specific Protease 7 Induces Ferroptosis in Gastric Cancer via Targeting Stearoyl-CoA Desaturase. Adv. Sci. 2024, 11, e2307899. [Google Scholar] [CrossRef] [PubMed]
- Beretta, G.L.; Costantino, M.; Mirra, L.; Pettinari, P.; Perego, P. Deubiquitinases in Ovarian Cancer: Role in Drug Resistance and Tumor Aggressiveness. Int. J. Biol. Sci. 2024, 20, 5208–5222. [Google Scholar] [CrossRef]
- Zhang, J.; Liu, B.; Ren, R.; Song, S.; Bao, X.; Huan, X.; Li, H.; Xu, J.; Yu, T.; Wang, R.; et al. Discovery and Optimization of a Series of Novel Morpholine-Containing USP1 Inhibitors. J. Med. Chem. 2025, 68, 3673–3699. [Google Scholar] [CrossRef]
- Shang, L.; Wang, Y.; Li, J.; Zhou, F.; Xiao, K.; Liu, Y.; Zhang, M.; Wang, S.; Yang, S. Mechanism of Sijunzi Decoction in the treatment of colorectal cancer based on network pharmacology and experimental validation. J. Ethnopharmacol. 2023, 302, 115876. [Google Scholar] [CrossRef]
- Issagholian, L.; Tabaie, E.; Reddy, A.J.; Ghauri, M.S.; Patel, R. Expression of E-cadherin and N-cadherin in Epithelial-to-Mesenchymal Transition of Osteosarcoma: A Systematic Review. Cureus 2023, 15, e49521. [Google Scholar] [CrossRef] [PubMed]
- Meng, Y.; Wang, Y.; Liu, L.; Wu, R.; Zhang, Q.; Chen, Z.; Yao, Y.; Li, X.; Gong, Y.; Li, H.; et al. Immunohistochemistry identifies E-cadherin, N-cadherin and focal adhesion kinase (FAK) as predictors of stage I non-small cell lung carcinoma spread through the air spaces (STAS), and the combinations as prognostic factors. Transl. Lung Cancer Res. 2024, 13, 1450–1462. [Google Scholar] [CrossRef]
- Chang, Y.P.; Huang, G.K.; Chen, Y.C.; Huang, K.T.; Chen, Y.M.; Lin, C.Y.; Huang, C.C.; Lin, M.C.; Wang, C.C. E-cadherin expression in the tumor microenvironment of advanced epidermal growth factor receptor-mutant lung adenocarcinoma and the association with prognosis. BMC Cancer 2023, 23, 569. [Google Scholar] [CrossRef] [PubMed]
- Nam, M.W.; Kim, C.W.; Choi, K.C. Epithelial-Mesenchymal Transition-Inducing Factors Involved in the Progression of Lung Cancers. Biomol. Ther. 2022, 30, 213–220. [Google Scholar] [CrossRef]
- Santos, E.; Nogueira, K.; Fernandes, L.; Martins, J.; Reis, A.; Neto, J.; Junior, I.; Pessoa, C.; Petrilli, R.; Eloy, J.O. EGFR targeting for cancer therapy: Pharmacology and immunoconjugates with drugs and nanoparticles. Int. J. Pharm. 2021, 592, 120082. [Google Scholar] [CrossRef] [PubMed]
- Takeuchi, K.; Ito, F. EGF receptor in relation to tumor development: Molecular basis of responsiveness of cancer cells to EGFR-targeting tyrosine kinase inhibitors. FEBS J. 2010, 277, 316–326. [Google Scholar] [CrossRef] [PubMed]
- Fang, Z.; Meng, Q.; Xu, J.; Wang, W.; Zhang, B.; Liu, J.; Liang, C.; Hua, J.; Zhao, Y.; Yu, X.; et al. Signaling pathways in cancer-associated fibroblasts: Recent advances and future perspectives. Cancer Commun. 2023, 43, 3–41. [Google Scholar] [CrossRef]
- Bahar, M.E.; Kim, H.J.; Kim, D.R. Targeting the RAS/RAF/MAPK pathway for cancer therapy: From mechanism to clinical studies. Signal Transduct. Target. Ther. 2023, 8, 455. [Google Scholar] [CrossRef]
- Kim, N.Y.; Mohan, C.D.; Chinnathambi, A.; Alharbi, S.A.; Sethi, G.; Rangappa, K.S.; Ahn, K.S. Euphorbiasteroid Abrogates EGFR and Wnt/beta-Catenin Signaling in Non-Small-Cell Lung Cancer Cells to Impart Anticancer Activity. Molecules 2022, 27, 3824. [Google Scholar] [CrossRef]
- Deldar Abad Paskeh, M.; Mirzaei, S.; Ashrafizadeh, M.; Zarrabi, A.; Sethi, G. Wnt/β-Catenin Signaling as a Driver of Hepatocellular Carcinoma Progression: An Emphasis on Molecular Pathways. J. Hepatocell. Carcinoma 2021, 8, 1415–1444. [Google Scholar] [CrossRef] [PubMed]
- Zhao, F.Y.; Han, J.; Chen, X.W.; Wang, J.; Wang, X.D.; Sun, J.G.; Chen, Z.T. miR-223 enhances the sensitivity of non-small cell lung cancer cells to erlotinib by targeting the insulin-like growth factor-1 receptor. Int. J. Mol. Med. 2016, 38, 183–191. [Google Scholar] [CrossRef]
- Wang, Q.; Zhao, D.Y.; Xu, H.; Zhou, H.; Yang, Q.Y.; Liu, F.; Zhou, G.P. Down-regulation of microRNA-223 promotes degranulation via the PI3K/Akt pathway by targeting IGF-1R in mast cells. PLoS ONE 2015, 10, e123575. [Google Scholar] [CrossRef] [PubMed]
- Sun, D.; Tang, B.; Li, Z.; Guo, H.; Cheng, J.; Song, P.; Zhao, X. MiR-29c reduces the cisplatin resistance of non-small cell lung cancer cells by negatively regulating the PI3K/Akt pathway. Sci. Rep. 2018, 8, 8007–8009. [Google Scholar] [CrossRef] [PubMed]
- Lin, Y.; Zhang, L.; Ding, X.; Chen, C.; Meng, M.; Ke, Y.; Wang, W. Relationship between the microRNAs and PI3K/AKT/mTOR axis: Focus on non-small cell lung cancer. Pathol. Res. Pract. 2022, 239, 154093. [Google Scholar] [CrossRef]
- Lange, S.M.; Armstrong, L.A.; Kulathu, Y. Deubiquitinases: From mechanisms to their inhibition by small molecules. Mol. Cell 2022, 82, 15–29. [Google Scholar] [CrossRef] [PubMed]
- Chen, S.; Liu, Y.; Zhou, H. Advances in the Development Ubiquitin-Specific Peptidase (USP) Inhibitors. Int. J. Mol. Sci. 2021, 22, 4546. [Google Scholar] [CrossRef] [PubMed]
- Gao, H.; Yin, J.; Ji, C.; Yu, X.; Xue, J.; Guan, X.; Zhang, S.; Liu, X.; Xing, F. Targeting ubiquitin specific proteases (USPs) in cancer immunotherapy: From basic research to preclinical application. J. Exp. Clin. Cancer Res. 2023, 42, 225. [Google Scholar] [CrossRef] [PubMed]
- Schauer, N.J.; Magin, R.S.; Liu, X.; Doherty, L.M.; Buhrlage, S.J. Advances in Discovering Deubiquitinating Enzyme (DUB) Inhibitors. J. Med. Chem. 2020, 63, 2731–2750. [Google Scholar] [CrossRef] [PubMed]
- Harrigan, J.A.; Jacq, X.; Martin, N.M.; Jackson, S.P. Deubiquitylating enzymes and drug discovery: Emerging opportunities. Nat. Rev. Drug Discov. 2018, 17, 57–78. [Google Scholar] [CrossRef]
- Liu, F.; Chen, J.; Li, K.; Li, H.; Zhu, Y.; Zhai, Y.; Lu, B.; Fan, Y.; Liu, Z.; Chen, X.; et al. Ubiquitination and deubiquitination in cancer: From mechanisms to novel therapeutic approaches. Mol. Cancer 2024, 23, 148. [Google Scholar] [CrossRef]
- Mussell, A.; Shen, H.; Chen, Y.; Mastri, M.; Eng, K.H.; Bshara, W.; Frangou, C.; Zhang, J. USP1 Regulates TAZ Protein Stability Through Ubiquitin Modifications in Breast Cancer. Cancers 2020, 12, 3090. [Google Scholar] [CrossRef]
- Yuan, P.; Feng, Z.; Huang, H.; Wang, G.; Chen, Z.; Xu, G.; Xie, Z.; Jie, Z.; Zhao, X.; Ma, Q.; et al. USP1 inhibition suppresses the progression of osteosarcoma via destabilizing TAZ. Int. J. Biol. Sci. 2022, 18, 3122–3136. [Google Scholar] [CrossRef] [PubMed]
- Mrozik, K.M.; Blaschuk, O.W.; Cheong, C.M.; Zannettino, A.; Vandyke, K. N-cadherin in cancer metastasis, its emerging role in haematological malignancies and potential as a therapeutic target in cancer. BMC Cancer 2018, 18, 939. [Google Scholar] [CrossRef]
- Mukhtar, N.; Cytrynbaum, E.N.; Edelstein-Keshet, L. A multiscale computational model of YAP signaling in epithelial fingering behavior. Biophys. J. 2022, 121, 1940–1948. [Google Scholar] [CrossRef] [PubMed]
- Koh, Y.W.; Han, J.H.; Haam, S. Expression of PD-L1, cancer stem cell and epithelial-mesenchymal transition phenotype in non-small cell lung cancer. Pathology 2021, 53, 239–246. [Google Scholar] [CrossRef] [PubMed]
- Li, L.Y.; Guan, Y.D.; Chen, X.S.; Yang, J.M.; Cheng, Y. DNA Repair Pathways in Cancer Therapy and Resistance. Front. Pharmacol. 2020, 11, 629266. [Google Scholar] [CrossRef]
- Brabletz, S.; Schuhwerk, H.; Brabletz, T.; Stemmler, M.P. Dynamic EMT: A multi-tool for tumor progression. EMBO J. 2021, 40, e108647. [Google Scholar] [CrossRef] [PubMed]
- Kim, H.S.; Lee, S.I.; Choi, Y.R.; Kim, J.; Eun, J.W.; Song, K.S.; Jeong, J.Y. GNAQ-Regulated ZO-1 and ZO-2 Act as Tumor Suppressors by Modulating EMT Potential and Tumor-Repressive Microenvironment in Lung Cancer. Int. J. Mol. Sci. 2023, 24, 8801. [Google Scholar] [CrossRef] [PubMed]
- Tang, X.; Xiong, K. Intrauterine Growth Retardation Affects Intestinal Health of Suckling Piglets via Altering Intestinal Antioxidant Capacity, Glucose Uptake, Tight Junction, and Immune Responses. Oxid. Med. Cell. Longev. 2022, 2022, 2644205. [Google Scholar] [CrossRef]
- Slifer, Z.M.; Blikslager, A.T. The Integral Role of Tight Junction Proteins in the Repair of Injured Intestinal Epithelium. Int. J. Mol. Sci. 2020, 21, 972. [Google Scholar] [CrossRef] [PubMed]
- Malki, A.; ElRuz, R.A.; Gupta, I.; Allouch, A.; Vranic, S.; Al, M.A. Molecular Mechanisms of Colon Cancer Progression and Metastasis: Recent Insights and Advancements. Int. J. Mol. Sci. 2020, 22, 130. [Google Scholar] [CrossRef] [PubMed]
- Zhu, L.; Tian, Q.; Gao, H.; Wu, K.; Wang, B.; Ge, G.; Jiang, S.; Wang, K.; Zhou, C.; He, J.; et al. PROX1 promotes breast cancer invasion and metastasis through WNT/beta-catenin pathway via interacting with hnRNPK. Int. J. Biol. Sci. 2022, 18, 2032–2046. [Google Scholar] [CrossRef]
- Zhou, Y.; Xu, J.; Luo, H.; Meng, X.; Chen, M.; Zhu, D. Wnt signaling pathway in cancer immunotherapy. Cancer Lett. 2022, 525, 84–96. [Google Scholar] [CrossRef]
- Malumbres, M.; Barbacid, M. Cell cycle, CDKs and cancer: A changing paradigm. Nat. Rev. Cancer 2009, 9, 153–166. [Google Scholar] [CrossRef]
- Wang, H.; Guo, M.; Wei, H.; Chen, Y. Targeting p53 pathways: Mechanisms, structures, and advances in therapy. Signal Transduct. Target Ther. 2023, 8, 92. [Google Scholar] [CrossRef] [PubMed]
- Hassin, O.; Oren, M. Drugging p53 in cancer: One protein, many targets. Nat. Rev. Drug Discov. 2023, 22, 127–144. [Google Scholar] [CrossRef] [PubMed]
- Li, X.; Zhou, J.; Chen, Z.; Chng, W. p53 mutations in colorectal cancer-molecular pathogenesis and pharmacological reactivation. World J. Gastroenterol. WJG 2015, 21, 84–93. [Google Scholar] [CrossRef] [PubMed]
- Spitz, A.Z.; Gavathiotis, E. Physiological and pharmacological modulation of BAX. Trends Pharmacol. Sci. 2022, 43, 206–220. [Google Scholar] [CrossRef] [PubMed]
- Gu, M.; Liu, Y.; Xin, P.; Guo, W.; Zhao, Z.; Yang, X.; Ma, R.; Jiao, T.; Zheng, W. Fundamental insights and molecular interactions in pancreatic cancer: Pathways to therapeutic approaches. Cancer Lett. 2024, 588, 216738. [Google Scholar] [CrossRef]
- Deng, H.; Chen, Y.; Li, P.; Hang, Q.; Zhang, P.; Jin, Y.; Chen, M. PI3K/AKT/mTOR pathway, hypoxia, and glucose metabolism: Potential targets to overcome radioresistance in small cell lung cancer. Cancer Pathog. Ther. 2023, 1, 56–66. [Google Scholar] [CrossRef] [PubMed]
- Miricescu, D.; Totan, A.; Stanescu-Spinu, I.I.; Badoiu, S.C.; Stefani, C.; Greabu, M. PI3K/AKT/mTOR Signaling Pathway in Breast Cancer: From Molecular Landscape to Clinical Aspects. Int. J. Mol. Sci. 2020, 22, 173. [Google Scholar] [CrossRef] [PubMed]
- Asl, E.R.; Amini, M.; Najafi, S.; Mansoori, B.; Mokhtarzadeh, A.; Mohammadi, A.; Lotfinejad, P.; Bagheri, M.; Shirjang, S.; Lotfi, Z.; et al. Interplay between MAPK/ERK signaling pathway and MicroRNAs: A crucial mechanism regulating cancer cell metabolism and tumor progression. Life Sci. 2021, 278, 119499. [Google Scholar] [CrossRef]

Disclaimer/Publisher’s Note: The statements, opinions and data contained in all publications are solely those of the individual author(s) and contributor(s) and not of MDPI and/or the editor(s). MDPI and/or the editor(s) disclaim responsibility for any injury to people or property resulting from any ideas, methods, instructions or products referred to in the content. |
© 2025 by the authors. Licensee MDPI, Basel, Switzerland. This article is an open access article distributed under the terms and conditions of the Creative Commons Attribution (CC BY) license (https://creativecommons.org/licenses/by/4.0/).
Share and Cite
Wu, L.; Yu, M.; Liang, H.; Lin, L.; Li, H.; Chen, G.; Muhetaer, H.; Li, J.; Wu, B.; Jia, X.; et al. SJB2-043, a USP1 Inhibitor, Suppresses A549 Cell Proliferation, Migration, and EMT via Modulation of PI3K/AKT/mTOR, MAPK, and Wnt Signaling Pathways. Curr. Issues Mol. Biol. 2025, 47, 155. https://doi.org/10.3390/cimb47030155
Wu L, Yu M, Liang H, Lin L, Li H, Chen G, Muhetaer H, Li J, Wu B, Jia X, et al. SJB2-043, a USP1 Inhibitor, Suppresses A549 Cell Proliferation, Migration, and EMT via Modulation of PI3K/AKT/mTOR, MAPK, and Wnt Signaling Pathways. Current Issues in Molecular Biology. 2025; 47(3):155. https://doi.org/10.3390/cimb47030155
Chicago/Turabian StyleWu, Lipeng, Meng Yu, Huosheng Liang, Long Lin, Huajian Li, Guangyang Chen, Halimulati Muhetaer, Jingjing Li, Bo Wu, Xuejing Jia, and et al. 2025. "SJB2-043, a USP1 Inhibitor, Suppresses A549 Cell Proliferation, Migration, and EMT via Modulation of PI3K/AKT/mTOR, MAPK, and Wnt Signaling Pathways" Current Issues in Molecular Biology 47, no. 3: 155. https://doi.org/10.3390/cimb47030155
APA StyleWu, L., Yu, M., Liang, H., Lin, L., Li, H., Chen, G., Muhetaer, H., Li, J., Wu, B., Jia, X., Dang, Y., Zheng, G., & Li, C. (2025). SJB2-043, a USP1 Inhibitor, Suppresses A549 Cell Proliferation, Migration, and EMT via Modulation of PI3K/AKT/mTOR, MAPK, and Wnt Signaling Pathways. Current Issues in Molecular Biology, 47(3), 155. https://doi.org/10.3390/cimb47030155





